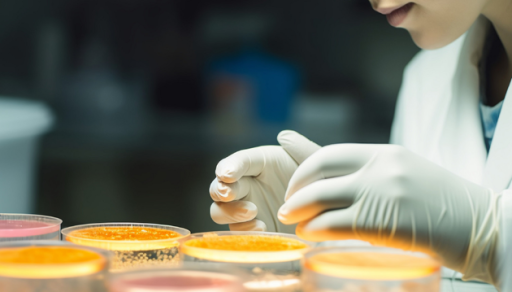
引入“时间维度”后，AI将迎来怎样的变革？

2014年从美国回来后,李金金就回到了母校上海交通大学任职,之后一直在上海教书、生活。2024年年初,她第一次去新疆,目的地是距离乌鲁木齐直线距离500多公里的伊宁。关于这趟长途旅行,她并非冲着早已红透互联网的那拉提、赛里木湖、薰衣草花海,而是位于川宁生物(301301.SZ)厂区内的几十个4层楼高、近500吨重的金属罐子。
在别人可能还在读博士的年纪,李金金29岁时就成为了上海交通大学里最年轻的博导、教授之一,如今主持着人工智能与微结构实验室(Artificial Intelligence and Micro Structure Laboratory,AIMS-Lab)。近期,她解决发酵行业的一个百年难题“黑箱白化”,这一技术填补了全球AI技术在“时序依赖型工业控制”中的空白。
从“试错模式”到“智能模式”
近年来,我国不断出台相关政策,支持叠加技术突破,不断推动技术创新与产业落地深度融合,进一步巩固技术应用优势,为我国新一轮产业革命注入了强劲动力。
发酵技术作为生物制造的核心手段,广泛应用于食品、医药、能源及化工领域。在医药领域,生物发酵是抗生素(如青霉素)、疫苗、基因治疗载体等生产的核心工艺。中国生物发酵产业规模稳居全球首位,年产量超7000万吨,氨基酸、维生素等核心产品占全球总量60%-80%。
我国拥有相关产业链的完整性与规模化生产能力,具有国际竞争的核心优势。“但和一般制造业(如钢铁冶炼、机械制造、石油加工等)往往只需要流程明确、把控参数、遵循原理、规范操作,即可基本保证产出和质量所不同,生物发酵领域极为特殊,它是受时间因素影响较大,微生物在各生长阶段的差异性巨大。”李金金对第一财经称,数百年来,人类发酵工程师始终极其依赖于固定参数与人工经验,但依然难以应对微生物代谢的动态变化,这也成为了工业生产领域难度最大的环节之一,“甚至毫不夸张地说,哪个国家能在发酵领域掌握最新技术,那么这个国家,就能在全球最‘高精尖’的生物制造领域抢得先机。”
川宁生物是全球最大的抗生素中间体发酵企业,也是我国抗生素链主企业。李金金回忆称,进入厂区的第一印象是,“在祖国的西部边疆能有这样一个大型科技企业,让像我这样一个一直在大学里做人工智能研究的科技工作者感到挺吃惊。”
让李金金更为惊讶的是,在如此偏远地区,有近3000名高素质工程师在工作,且是24小时轮班工作。“他们真的非常辛苦。我记得,当时企业管理者告诉我,他最怕半夜里接到电话,那就意味着可能出事故了。对他而言,能睡个安稳觉是个难得的美事。”事实上,川宁生物在安全保障、降低事故率以及提高工人操作熟练度方面已经投入了大量的人力和物力成本,已然是国内在这一细分领域中最优秀的企业之一。
“但哪怕是经验再丰富的工程师,在调整发酵过程时,也不可避免地会出错,那么失误率和事故率也会跟着变高,最终导致产量不可控。川宁生物的抗生素发酵周期长达七天,即便经验丰富的工程师从第一天一直跟进到第七天,也很难确定最终产量。”那时,李金金意识到,整个发酵过程极为复杂,“属于高维度、复杂、非线性问题。对于7天的发酵周期,一天24小时,每分每秒都很关键,而且发酵参数众多。我当时就想,如果能用人工智能代替人类的部分工作,那对整个发酵行业将产生极为重大的影响,起码工程师们不用再三班倒了,事故率可以大大降低。更重要的是,每一批次的产量可控性大大增强,我们想要达到什么样的产量,在提前进行数据运算时就能预测出来。这样一来,生产的可控性、操作性和清晰性都会有极大提升,产量也会相应提高。”
经过一年多时间的联合研究开发,双方共同打造的“基于迁移学习和物理可解释的小样本AI工业自动控制系统”(下称“该AI自控系统”)终于发挥出了巨大效用川宁生物在刚刚发布的2024年报中称,“该公司在硫氰酸红霉素产线部分实验罐上实现了AI动态调控,使得在复杂的生物发酵过程中能动态调控参数,实时生成了最优的发酵方案,从而提升硫氰酸红霉素实验罐发酵产量。
川宁生物总经理邓旭衡对第一财经称,从目前实验数据来看,由该AI虚拟工程师所调控的实验罐的发酵水平已全部高于原有未使用AI调控发酵罐水平,按照相同物料投入,AI所调控的发酵罐平均产量超出对照组3%-5%的产量,并且随着新批次数据的喂入,多次迭代后有望持续提升发酵产量。
邓旭衡进一步解释称:“当AI系统基于我们的历史数据构建的模型落地时,短短30天便实现了这一(3%-5%)产量的提升,这是宣告人工智能在发酵领域的全面觉醒AI虚拟工程师的入驻,彻底终结了生产数据的混沌波动,构建起稳定且高产的数据闭环。那么,随着AI系统在稳定高产的数据持续喂养下不断迭代,产量提升曲线会以很快的曲率上扬,从5%、10%、15%……按照公司每年近60亿产值预估,提升10%对应提升20%以上的净利润水平。AI会以人类难以企及的速度与精度,无限逼近发酵工艺的理论极限,将原本遥不可及的技术天花板,转化为持续突破的新起点,彻底颠覆人类对工业生产的传统认知边界。”
邓旭衡说道,未来AI系统还会持续迭代,可以进一步烫平生产波动,提高发酵水平和提取收率,“AI系统在硫红生产线已经得到验证,近期会开展头孢、青霉素等生产线的迁移,全面‘接管’我们的发酵生产线,持续提高川宁的生产效益,巩固和提升我们国家的相关产业在全球产业链中龙头地位。”
随着AI技术与生物制造的深度融合,发酵生产正从依赖经验的“试错模式”向数据驱动的“智能模式”转型。这一转型不仅重塑了生产流程,更催生了生物制造领域的技术革命。
引入“时间维度”概念的AI
人工智能在工业上的应用,本质上是一场生产关系的革命。以该AI自控系统为例,它不但使得发酵技术不再局限于现有产品的效率提升,而且打开生物制造“设计构建测试学习”的创新空间,更是还能通过AI控制的标准化发酵流程,来推动中国主导制定国际生物制造质量控制标准。
“生物发酵技术是生物制造的基石,该AI自控系统使中国相关企业牢牢占据抗生素、酶制剂等关键生物产品生产中的技术制高点,通过该AI自控系统提升产量与良率,可进一步巩固‘中国供应全球需求’的格局,迫使一些西方大国在加征关税时面临其国内医药、饲料行业成本激增的反制压力。”李金金如是说。
在李金金看来,更为重要的是,该AI自控系统首次将“时间维度”引入工业控制领域,解决了生物发酵这一复杂动态过程的实时预测与调控的国际难题。“这打破了人类经验主义,以及‘无法考虑时间因素’的主流AI大语言模型的束缚,将生物制造推进至‘模型定义生产’的新阶段。”李金金说,这也趟出了一条适合中国国情的、依靠自主创新、节约算力成本,巩固和提升在全球产业链中龙头地位的道路。
简而言之,该AI自控系统已成为事实上的工业控制“智驾系统”。“不但能回顾过往,还能预判将来,使得在复杂的生物发酵过程中,能动态调控参数,实时生成了最优的发酵方案,从而大幅提升生物发酵的产量。”李金金称,在该AI自控系统使得相关企业的效率大大提升的同时,和目前比较主流的、动辄需要几千块(甚至几万块)GPU卡才能运行的AI大模型所不同的是,该AI自控系统只需要十几张GPU卡和传统AI模型中5%的数据,就可以实现连续、精准的推理预测。这就极大降低了我国工业企业在算力资源上的投入成本,直接降低企业智能化改造成本,为快速部署低成本、高效能的“AI工业大脑”提供了重要的经验,助力中小型企业技术升级。
该AI自控系统其所具备的小数据处理、可解释性、轻量化以及内嵌时间维度的优势,打破了对海量数据和超算资源的依赖,为中国AI技术提供了一条低成本、高能效的工业化路径,避免陷入西方主导的算力的“大模型军备竞赛”。
“AI+工业化”成为增长新引擎
近年来,在国家大量积极、有效的政策引导下,我国的生物制造技术持续向高附加值领域发展,从基础化学品到高端医疗材料,产业链上下游协同创新。新一代通用人工智能多维度的技术演进,将重塑智能经济格局。目前,通用人工智能发展进入新阶段,呈现出多模态融合、跨学科交叉、人机协同、群智开放、自主学习等新特征。
通过“模型定义生产”模式,推动制造业从“流程标准化”向“动态智能化”转型,为中国AI技术落地工业场景(尤其是生物制造等高精尖领域)树立标杆,使得该AI自控系统能够迅速应用到其他工业场景之中,进而对中国工业体系带来新局面。例如:合成生物、生物医药、食品工业、芯片制造、大量传统制造业、环保产业领域等。
上海交通大学副校长曾小勤对第一财经记者表示:“这项工作对于把人工智能列为重点支撑行业的上海而言,将会产生重大且意义深远的影响。借助人工智能技术,上海有能力助力更多中国制造企业实现集体产业升级,促使它们迈向国际领先水平,在国际上享有更多话语权,极大的推动经济发展。具体而言,一方面,该项工作能够推动上海建设人工智能科创中心的产业规模持续拓展,为相关产品与服务开辟出更为广阔的市场空间;另一方面,它还可以加速技术的迭代创新进程,使技术更好地贴合工业领域的现实需求,助力中国工业加快迈向链主地位的脚步,进一步强化产业集群效应,提升区域经济的辐射带动能力。通过这些举措,上海以人工智能为技术依托,为其他省市进行产业赋能的独特优势得以充分展现,也展示了上海在技术创新以及合作交流方面的担当。”
人工智能是上海三大先导产业之一,也是上海建设国际科创中心的重要支撑。在上海,已将“AI+工业化”视为实现制造业能级跃升的核心引擎,AI技术在上海各领域的应用已经取得了显著进展,呈现出广泛而深入的发展态势。
为前瞻布局一批新一代通用人工智能关键任务,加快建设人工智能上海高地,打造人工智能世界级产业集群,上海市经济和信息化委员会于近日(4月21日)发布关于开展2025年新一代通用人工智能创新任务揭榜挂帅工作的通知。本次揭榜挂帅面向5个揭榜方向,包括具身智能、科学智能、空间智能、群体智能和类脑智能。征集并遴选一批具备较强创新能力的单位集中攻关,推动新一代人工智能关键技术突破,加速新技术、新产品落地应用。
毫无疑问,上海已经成为了全球AI目光的汇聚地。
李金金说她有着一个颇具“野心”的想法:“中国作为制造业大国,在生产过程中,往往不可避免地会遭遇一些阻碍企业发展前行的重大瓶颈。其中,有些属于静态的科学问题,还有些则如同发酵一般,是和时间动态相关的科学问题。如果中国的制造业都能借助人工智能的强大力量,实现集体性的产业升级,进而催生出更多的链主企业,那么中国便能在国际上拥有更多的话语权,能够通过这种方式实现‘科技报国’,无疑是一名科技工作者的终极梦想。”
(本文来自第一财经)










评论前必须登录!
注册